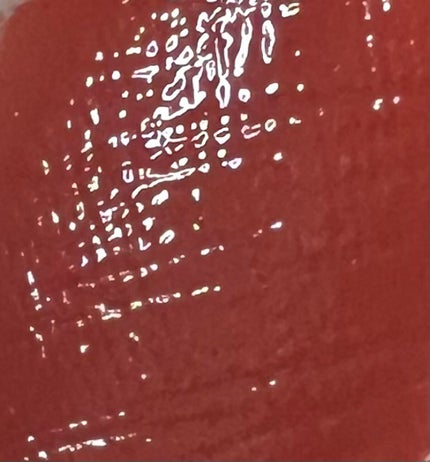
西西é
±ð on LIPS ãdiro740ð#ã¯ãããŠã®æçš¿..ãïŒ5æç®ïŒ

ã¿ããªã®åœ¹ã«ç«ã¡ããïŒãæ°è»œã«ã³ã¡ã³ããã ããð¥¹ð#ã¯ãããŠã®æçš¿...
ãã£ãšèŠãè¥¿è¥¿é ±ðããã®äººæ°ã¯ãã³ã
diro740ð#ã¯ãããŠã®æçš¿...
ãã£ãšèŠã
65
0
- 2022.12.08
suikoÃbiople#01ã¢ã€ã·ã£ããŒãã©ãã©ã§ã...
ãã£ãšèŠã
55
0
- 2022.12.08
ðURBANDECAYSINGEãã©ãã©ã®å£çŽ ...
ãã£ãšèŠã
53
1
- 2022.12.16
ã±ã€ããããªããã¢ã³ã¹ã¿ãŒ05880å...
ãã£ãšèŠã
53
0
- 2022.12.20
BOBBIBROWNãããªãã#01...
ãã£ãšèŠã
46
0
- 2023.03.09
Diroã¢ã€ã·ã£ããŒ#667ãšãŠãç¹å¥ãªè²...
ãã£ãšèŠã
44
0
- 2023.03.08
![LIPS[ãªããã¹] - ã³ã¹ã¡ã®ã¯ãã³ãæ€çŽ¢ã¢ããª](https://cloudflare.lipscosme.com/assets/lips_logo_full_2022-bc7b4bc9dd66035bc5696b0d16bc3d38a7be357186656c039e68cc4cf21ae675.png)

ã³ã¡ã³ã